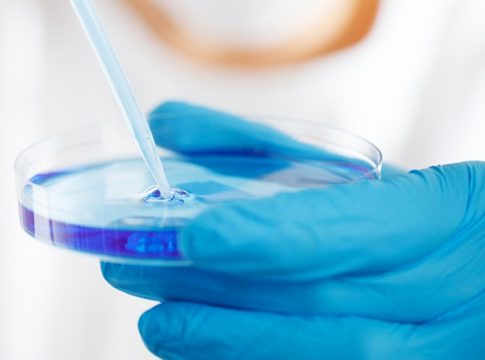
84

El Foro Química y Sociedad, entidad que representa a entidades de la química española en el ámbito académico, científico, institucional e industrial, ha organizado el XVIII acto oficial de celebración del Día de la Química 2020.
Según ha informado la entidad, el acto ha tenido lugar en el marco de Unprecedented Virtual Forum, la serie de sesiones virtuales organizadas por el Encuentro Internacional de la Química - Expoquimia con motivo de la Semana de la Ciencia.
Así, ha explicado que El Día de la Química 2020, al que se han asistido más de 400 espectadores únicos, ha contado con la inauguración de Carles Navarro, presidente de Expoquimia y de Feique y director general de BASF Española; Raül Blanco, secretario general de Industria y de la Pequeña y Mediana Empresa del Ministerio de Industria, Comercio y Turismo (MINCOTUR); y Carlos Negro, presidente del Foro Química y Sociedad.
En su intervención, Raül Blanco ha reconocido la labor del sector químico para plantar cara a la crisis sanitaria y económica que ha producido la pandemia. "La industria química debe estar en primera línea de la recuperación tras el Covid-19", ha declarado.
Por su parte, Carles Navarro ha puesto en valor el papel esencial del sector químico "para garantizar la continuidad de las cadenas de suministro y como palanca fundamental para construir un modelo social y económico más inclusivo y sostenible a todos los niveles". "Un camino sin retorno más allá de la pandemia", ha apostillado.
También Carlos Negro ha reconocido el trabajo de los empleados del sector durante la pandemia ya que, "aunque ha sido un año difícil, la Química ha demostrado su papel esencial más que nunca". "Hoy nos podemos sentir muy orgullosos", ha afirmado.
Durante el acto, se han anunciado los galardonados con los Premios Equiplast 2020 - Shaping the Future, los Premios Expoquimia 2020 - Negocio y Ciencia, la fusión perfecta; y se han entregado los Premios ANQUE 2020 y 75 Aniversario ANQUE.
El presidente de la Asociación Nacional de Químicos e Ingenieros Químicos de España, Ernesto Castañeda, ha hecho entrega del Premio 75 Aniversario ANQUE a Rey Felipe VI, en agradecimiento a su apoyo incondicional a la profesión química durante los años que ha presidido todos los Congresos Nacionales e Internacionales de Química celebrados en España.
Castañeda también ha entregado el Premio ANQUE 2020 a Pedro Lozano Rodríguez, decano de la Facultad de Química de la Universidad de Murcia, por su intensa y fructífera actividad de difusión de la ciencia química.
El acto central de la ceremonia ha tenido lugar en la mesa redonda 'Química para afrontar el COVID-19: desafíos de una nueva era', moderada por la química y divulgadora científica Deborah García Bello, en el que han participado expertos de diferentes ámbitos de la química, que han puesto en valor el papel de esta área esencial de la ciencia y la industria para plantar cara a la pandemia de COVID-19 desde sus diferentes perspectivas.
En el debate han participado Ricardo Díaz Martín, decano del Colegio de Químicos de Madrid; Margarita del Val, química, viróloga, inmunóloga, e investigadora científica del Consejo Superior de Investigaciones Científicas (CSIC); Francisco J. Fernández, director de Comunicación de la Asociación Nacional Empresarial de la Industria Farmacéutica (Farmaindustria) y Álvaro Martínez del Pozo, catedrático de Bioquímica y Biología Molecular de la Facultad de Ciencias Químicas de la Universidad Complutense de Madrid.
Los especialistas han coincidido en la necesidad de "tratar como adultos a la sociedad" y han hecho un llamamiento a las administraciones y medios de comunicación para "ser realistas con las medidas que se han de tomar", generando un mensaje coordinado para la población, con la finalidad de prevenir los contagios en los entornos laborales y educativos, dotar de la importancia que merece a la transmisión aérea de la enfermedad por aerosoles y ser transparentes ante la posibilidad de una vacuna efectiva en el corto plazo.
La sesión ha sido clausurada por representantes de los organizadores y miembros del Foro Química y Sociedad a través de Marian Iriarte, miembro de la Junta Directiva de la Conferencia Española de Decanos de Química, y Antonio Deusa Pedrazo, vicesecretario general de UGT-FICA, quien ha hablado en nombre de todas las organizaciones representantes de los trabajadores de la Química.